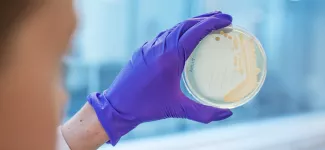

Today, the Government of Canada announced a significant investment in Canadian science, research and engineering. Over 4,800 lead researchers and their teams across the country will receive a total of $635 million in funding, including more than 3,400 new grants and grant extensions through the Natural Sciences and Engineering Research Council of Canada’s (NSERC) Discovery Grants program.
Eighty-five projects led by UBC researchers have received funding, including projects led by UBC Pharm Sci professors Drs. Judy Wong and Adam Frankel. Dr. Wong will receive an NSERC Discovery Grant of $160,000 across five years for her project titled “Structure-Function Relationship Study of Telomerase Reverse Transcriptase's Non-Canonical Activities.” Dr. Frankel will receive an NSERC Research Tools and Instruments Grant totalling $144,803 in support of his project “Biomolecular Imaging System for Nanomedicine and Chemical Biology Applications in Pharmaceutical Sciences.”
Upon announcing the recipients, the Honourable François-Philippe Champagne, Minister of Innovation, Science and Industry noted that “…it is inspiring to see the ingenuity and dedication Canadian researchers embrace in exploring big ideas that will fuel the discoveries and innovations of tomorrow to make our world a better place and create prosperity for Canadians.”
Other funding programs announced today include the Canada Research Chairs program, SSHRC Insight Grants, Insight Development Grants, Partnership Grants, and Partnership Development Grants programs. As a whole, projects led by UBC researchers received approximately $48 million of the $635 million funding total.
To learn more about the Government of Canada’s investment in Canadian science, research, and engineering, click here.